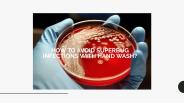
Smart and a Fail-Proof Protection from Superbug Infection

File to download:
Title: Smart and a Fail-Proof Protection from Superbug Infection - PowerPoint PPT Presentation
Description: Savoncare is Liquid Hand Wash Manufacturers in India, who are dedicated to providing liquid soap that is sophisticated for the hands ensuring it is gentle to use on hands – PowerPoint PPT presentation
Download instruction:
When the PPT version of this presentation was uploaded to PowerShow.com, it was checked for
viruses. That said, we cannot guarantee that the PPT file is safe for you to download. But if you
whish to download it, just check that you are not a robot and then click the download button.